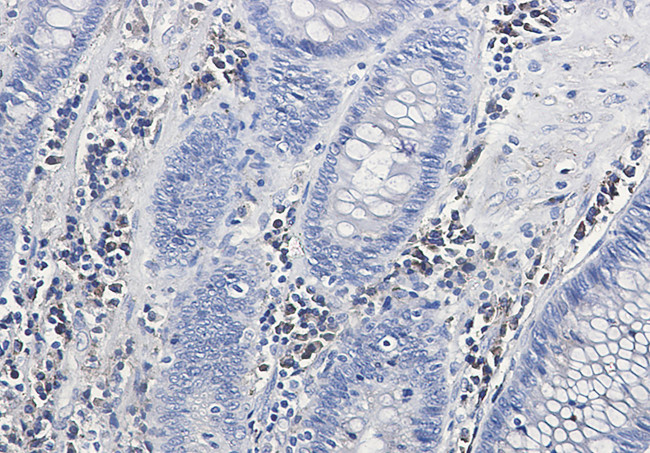
Calumenin Antibody in Immunohistochemistry (Paraffin) (IHC (P))

Search
Invitrogen
Calumenin Recombinant Rabbit Monoclonal Antibody (K01_2L65)
{{$productOrderCtrl.translations['antibody.pdp.commerceCard.promotion.promotions']}}
{{$productOrderCtrl.translations['antibody.pdp.commerceCard.promotion.viewpromo']}}
{{$productOrderCtrl.translations['antibody.pdp.commerceCard.promotion.promocode']}}: {{promo.promoCode}} {{promo.promoTitle}} {{promo.promoDescription}}. {{$productOrderCtrl.translations['antibody.pdp.commerceCard.promotion.learnmore']}}
图: 1 / 2
Calumenin Antibody (MA564014) in IHC (P)


产品信息
MA564014
种属反应
宿主/亚型
Expression System
分类
类型
克隆号
抗原
偶联物
形式
浓度
规格
纯化类型
保存液
内含物
保存条件
运输条件
RRID
靶标信息
Caluminin is a 315 amino acid Ca2+-binding member of the CREC, EF-hand protein family. Calumenin is a secreted protein t hat contains six Ca2+-binding (EF-hand) motifs and is expressed in the lumen of the endoplasmic reticulum (ER) and Golgi apparatus. In the presence of Ca2+, Calumenin interacts with serum amyloid P component (SAP) and, together, they may play a role in the immunological defense system and participate in amyloidosis, the pathological formation of amyloid deposits in different types of tissues. Calumenin has an inhibitory effect on the vitamin K-dependent g-carboxylation system which converts vitamin K-dependent proteins to Gla-containing proteins. Calumenin may also be involved in the pathophysiology of thrombosis and/or wound healing by acting in an autocrine or paracrine manner.
仅用于科研。不用于诊断过程。未经明确授权不得转售。
篇参考文献 (0)
生物信息学
蛋白别名: CALU; Calumenin; CBP-50; Crocalbin; crocalbin-like protein; IEF SSP 9302; multiple EF-hand protein; reticulocalbin; unnamed protein product
基因别名: CALU; Cbp50; Rcn
UniProt ID: (Human) O43852
Entrez Gene ID: (Human) 813, (Rat) 64366